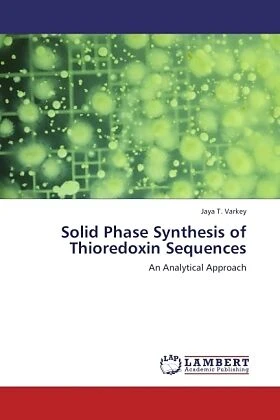

Wir verwenden Cookies und Analyse-Tools, um die Nutzerfreundlichkeit der Internet-Seite zu verbessern und für Marketingzwecke. Wenn Sie fortfahren, diese Seite zu verwenden, nehmen wir an, dass Sie damit einverstanden sind. Zur Datenschutzerklärung.
Solid Phase Synthesis of Thioredoxin Sequences
Details
It has been nearly fifty years since the advent of solid phase method for the assembly of peptides. One of the main difficulties facing researchers in this field is that of obtaining quantities of peptides and proteins in a pure state. Isolation of proteins form natural resources can be laborious and often provides only tiny quantities. Investigations dealing with the quantitative aspects of polymer-supported reactions have shown that the insoluble support does have a significant dynamic influence on the bound substrates. An efficient polymeric support for peptdide synthesis should have optimum hydrophobic-hydrophilic balance compatible with the peptide being synthesized. This book illustrates the synthesis and characterization of a novel polymer support, polystyrene crosslinked with 1,6-hexanediol diacrylate for the successful synthesis of peptides. The compatibility of the new support is proved by synthesizing sequences of Thioredoxin, which is otherwise difficult to synthesize. Thioredoxin is a naturally occurring sulphur reducing protein containing 108 amino acids. The book is useful to researchers, scientists and academia in studying the intricacies of solid phase synthesis.
Autorentext
Jaya T. Varkey Ph.D:Graduated in Chemistry (Cochin University of Science and Technology, India), PhD in Chemistry (Chemical Sciences, M. G. University, Kerala, India), Post Doctoral Fellow (University of Minnesota, USA). National Young Scientist award winner (1995). Currently Assistant Professor in Chemistry, St. Teresa's College, Kerala, India.
Weitere Informationen
- Allgemeine Informationen
- GTIN 09783845428840
- Sprache Englisch
- Genre Chemie
- Größe H220mm x B150mm x T9mm
- Jahr 2011
- EAN 9783845428840
- Format Kartonierter Einband
- ISBN 3845428848
- Veröffentlichung 18.08.2011
- Titel Solid Phase Synthesis of Thioredoxin Sequences
- Autor Jaya T. Varkey
- Untertitel An Analytical Approach
- Gewicht 227g
- Herausgeber LAP LAMBERT Academic Publishing
- Anzahl Seiten 140